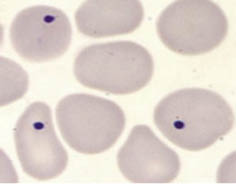

|
| Regreso a las bases |
M. Melo Valls*, T. Murciano Carrillo**
*Servicio de Oncohematología Pediátrica. **Servicio de Pediatría.
Hospital de Sabadell. Corporació sanitària Parc Taulí. Sabadell. Barcelona
Pediatr Integral 2012; XVI(5): 413.e1-413.e6
Interpretación del hemograma
Introducción
El hemograma, con todos sus parámetros, que se analizan según su normalidad o patología, pueden detectar posibles trastornos que ayudarán al diagnóstico de diversas patologías.
Como todas las herramientas que podemos usar en medicina, se debe utilizar de forma racional, selectivamente y para beneficio del niño. Plantearemos su realización en pacientes ambulatorios cuando haya sintomatología que lo justifique, si hay sospecha de enfermedades hematológicas o infecciosas o para monitorización de respuesta de algunos tratamientos.
La repetición de pruebas se debería limitar a los casos con curso clínico incierto. En aquellos que requieren un seguimiento se deberá realizar con el intervalo suficiente para que pueda ayudar en la toma de decisiones.
Los analizadores automáticos permiten cuantificar, con un elevado grado de fiabilidad, los principales parámetros hematológicos: recuento celular de hematíes, leucocitos y plaquetas, concentración de hemoglobina y los índices eritrocitarios de Wintrobe (volumen corpuscular medio, hemoglobina corpuscular media y concentración de hemoglobina corpuscular media).
Gracias a los analizadores, se ha reducido el número de fórmulas realizadas manualmente; sin embargo, el ojo humano sigue siendo imprescindible para detectar una buena parte de las alteraciones morfológicas que aparecen al observar una extensión de sangre periférica(1).
Serie roja
La principal función es transportar mediante la hemoglobina el oxígeno a los tejidos.
Recuento de hematíes (He)
Se expresa como He x 1012/L. La vida media es de 120 días. Se encuentra aumentado en número (poliglobulia) en las talasemias, en las cardiopatías, habitantes de grandes alturas, en estados de deshidratación y menos en las anemias ferropénicas. En cambio, en las anemias megaloblásticas se encontrará disminuido.
Hemoglobina (Hb)
Es una ferroproteína situada en el interior de los hematíes, encargada del transporte de oxígeno hacia los tejidos. Es el mejor parámetro para valorar la anemia, aunque la cifra de eritrocitos sea normal o incluso elevada. Se expresa en g/L de sangre. En los casos de anemia estará disminuida y en la poliglobulia estará elevada.
Hematocrito (Hto)
Es el volumen de elementos formes (hematíes) en relación a la cantidad de plasma. Se expresa en L/L. Se encontrará aumentado en las poliglobulias, ya sean falsas por hemoconcentración, verdaderas en aquellos casos donde el Hto es superior a 0,60 L/L o fisiológicas como en los recién nacidos (Tabla I).

Índices eritrocitarios de Wintrobe
Partiendo de la Hb, He y Hto se calculan una serie de índices útiles en la práctica clínica.
Volumen corpuscular medio (VCM)
Se calcula a partir del Hto y del número de hematíes (VCM = Hto x 1.000/ He). Se expresa en fl (fentolitro = 10-15 L). Un VCM elevado indica macrocitosis (hematíes grandes), siendo el caso de anemias megaloblásticas, anemias hemolíticas y en hepatopatías. En el recién nacido, la macrocitosis es fisiológica. En las microcitosis (hematíes pequeños), los valores están disminuidos, como en anemias ferropénicas y en talasemias.
Hemoglobina corpuscular media (HCM)
Se calcula a partir de la hemoglobina y del número de hematíes (HCM = Hb/He). Se expresa en pg (picogramo = 10-12 g). Se correlaciona con el VCM, ya que informa del contenido medio de hemoglobina de cada hematíe, por este motivo, estará alterado en los mismos casos.
Concentración de hemoglobina corpuscular media (CHCM)
Indica la concentración de hemoglobina por el total de masa de He (CHCM = Hb/Hto). Se expresa en g/L, siendo los parámetros de normalidad 330 ± 20 g/L. Valores aumentados (hipercromía) se observan exclusivamente en la esferocitosis. Valores disminuidos indican hipocromía, como en el caso de las anemias ferropénicas.
Otros índices de utilidad calculados actualmente por el autoanalizador:
Amplitud de distribución del tamaño de los eritrocitos (ADE o RDW)
Cuantifica la anisocitosis. Se expresa en porcentaje, siendo los valores normales 13 ± 1. Es un parámetro muy importante en el diagnóstico de las talasemias, donde será =15%.
Índice de dispersión de la Hb o distribución de Hb en los hematíes (HDW)
Se expresa en g/L con valores de normalidad entre 27 ± 5 g/L. Alterado cuando hay una doble población de hematíes, como es el caso de los pacientes transfundidos. También, lo observaremos en las anemias ferropénicas en tratamiento.
Morfología de los hematíes
Los eritrocitos normales son discos bicóncavos fácilmente deformables. La morfología de estos, ya sea por tamaño o forma, nos permite diagnosticar anemias, así como patologías que conllevan alteración de la membrana del hematíe (Fig. 1).

Figura 1. Morfología del hematíe y patología relacionada.
Los corpúsculos de Howell-Jolly son restos de núcleo del eritroblasto que normalmente el bazo se encarga de eliminar. Por este motivo, se encuentran en los esplenectomizados, anesplénicos y en los afectos de anemia hemolítica (Fig. 2). En pacientes afectos de malaria, puede observarse el protozoo (plasmodium) en el frotis de sangre periférica (Fig. 3).
Figura 2. Corpúsculos de Howell-Jolly.

Figura 3. Hematies infectados por Plasmodium.
Reticulocitos
Son hematíes jóvenes, no totalmente maduros. Su recuento es importante en el estudio de anemias y en la monitorización de su tratamiento; ya que, nos informa de la capacidad eritropoyética de la médula ósea. El valor normal 55 ± 20 x 109/L (1 ± 0,5%).
Un descenso se observa en anemias ferropénicas no tratadas, aplasias y leucemias. Aumentan en la anemia hemolítica, anemia hemorrágica intensa, después de una esplenectomía, en anemias ferropénicas en tratamiento y de forma fisiológica en el período neonatal.
Velocidad de sedimentación globular (VSG)
Se ha de valorar la 1ª hora. Los valores normales son 5-10 mm. Es un parámetro muy inespecífico, por lo que la podemos encontrar alterada en diversos procesos: infecciones, colagenosis, leucosis, tumores con participación hematológica, anemias y período post-prandial. En las poliglobulias y en el período neonatal (fisiológico), se encontrará disminuida.
Serie blanca
Los leucocitos son células presentes en sangre cuya función es la defensa del organismo frente a las agresiones del medio externo. Su estudio nos ayudará principalmente al diagnóstico de los procesos hematológicos e infecciosos(2,3).
Recuento de leucocitos (Le)
Se expresa en Le x 109/L, siendo los valores normales de 4 a 10 x 109/L (Tabla II). Se denomina leucopenia cuando se encuentran cifras inferiores a 4 x 109/L y leucocitosis a cifras superiores a 10-12 x 109/L. La vida media de los leucocitos es de seis a siete horas; por tanto, una fórmula leucocitaria puede variar completamente en este período.

La leucopenia puede ser indicativa de leucosis o infecciones. Tanto virus como bacterias pueden asociarse a leucopenia, pero en el último caso es sugestivo de infección grave. La leucocitosis puede ser fisiológica en el recién nacido y también se observa en: infecciones bacterianas, tos ferina, mononucleosis infecciosa, leucosis, tratamientos con corticoides o tras esplenectomía.
Una reacción leucemoide es aquella en la que encontramos cifras de leucocitos mayores de 50 x 109/L como puede ser el caso de infecciones bacterianas, mononucleosis infecciosa, en la fase de recuperación de una agranulocitosis o, más recientemente, por tratamientos con factores estimulantes de colonias granulopoyéticas (G-CSF, GM-GSF).
Formula leucocitaria
Nos permite cuantificar los diferentes tipos de leucocitos (neutrófilos, linfocitos, basófilos, eosinófilos y monocitos). Normalmente, se expresa en porcentaje, aunque los valores absolutos (x 109/L) son más precisos.
La linfocitosis fisiológica del lactante y el niño pequeño, suele desaparecer a partir de los 8 años, momento en el que la cifra de neutrófilos va aumentando y la de linfocitos disminuyendo equiparándose a la fórmula de los adultos.
La presencia de neutrófilos jóvenes se conoce como desviación a la izquierda y puede indicar la presencia de una infección bacteriana. Si la granulación de los neutrófilos es prominente, se denomina granulación tóxica e indica igualmente infección. Menos frecuente son los cuerpos de Döhle (manchas basófilas) presentes en algunas enfermedades hematológicas e infeccciones. La ausencia de neutrófilos en sangre periférica de denomina agranulocitosis.
Una hipersegmentación del núcleo se observa en las anemias megaloblásticas. La ausencia de segmentación se denomina anomalía nuclear de Pelger-Huët y no tiene trascendencia clínica, suele ser familiar y puede asociarse a algunas hemopatías.
La eosinofilia relativa es el ascenso de eosinófilos superior al 5%. Se encuentra en: parasitosis, hidatidosis, paludismo, patología alérgica o en el tratamiento con citostáticos. La ausencia de eosinófilos se puede observar en la apendicitis aguda y en la fiebre tifoidea.
En la monocitosis relativa encontramos valores superiores al 10%. Se halla siempre en la aplasia medular, tratamiento con citostáticos y en la mononucleosis infecciosa.
La linfocitosis puede indicar infección vírica, tos ferina o leucosis. Los linfocitos de tipo reactivo (estimulados) son de mayor tamaño, con núcleo voluminoso y citoplasma basófilo. Cifras superiores al 13% son características de la mononucleosis. La leucosis puede manifestarse con leucopenia o leucocitosis, siendo necesario identificar células blásticas para su diagnóstico.
Serie plaquetar
La función de las plaquetas es la hemostasia primaria, ayudando a la formación del tapón hemostático plaquetario.
Recuento de plaquetas (PLT)
Se expresan en PTL x 109/L. Los valores normales oscilan entre 150-400 x 109/L, siendo normales cifras hasta 500 x 109/L en niños. La vida media es de 8 a 11 días. Un número de plaquetas inferior a 100 x 109/L se denomina trombopenia y un valor superior a 400 x 109/L trombocitosis. Se resumen las principales causas en la tabla III.

Plaquetocrito (Ptc)
Se expresa en L/L. Corresponde al volumen de plaquetas en relación a la cantidad de plasma. Los valores normales oscilan entre 0,001-0,004 L/L.
Volumen plaquetar medio (VPM)
Se expresa en fl. siendo normal valores de 9 ± 2 fl. Un VPM elevado se observa en el caso de recuperación de trombopenia, en el síndrome de Bernard-Soulier, May-Hegglin y en la macrotrombopenia familiar.
Índice de dispersión de plaquetas o distribución de tamaño de plaquetas (PDW)
Se expresa en porcentaje y corresponde a la anisocitosis plaquetar. Los valores normales son: 45 ± 20%. Aumenta en las trombopenias en recuperación, en las trombocitosis y en algunas hemopatías.
Morfología plaquetar
La observación al microscopio nos podrá corroborar el resultado dado por el autoanalizador, siendo muy útil para identificar agregados plaquetares no cuantificados correctamente dando falsas plaquetopenias. También, permite detectar alteraciones en su tamaño y forma (plaquetas grises, degranuladas, dismórficas), que pueden indicar alteraciones en su funcionalidad, independientemente que el número sea normal.
Afectación simultánea de varias series. Pancitopenia
La pancitopenia es un trastorno en la formación de las tres series hematopoyéticas en la medula ósea y que se traduce en el hemograma por un descenso de éstas. Puede ser de causa central (aplasia), debido a radiaciones, tóxicos o virus (hepatitis), o de causa periférica, por procesos autoinmunes (síndrome de Evans), invasión medular (leucosis), hiperesplenismo o de causa idiopática.
Interpretación de la coagulación
Introducción
La función del sistema hemostático es mantener la sangre fluida en los vasos y detener la hemorragia, cuando existe lesión vascular, mediante la formación de un coágulo. Al romperse un vaso, se activan múltiples factores de coagulación, siendo el resultado la formación de un complejo de sustancias activadoras de la protrombina. Éstas catalizan la conversión de protrombina a trombina. La trombina actúa como enzima, convirtiendo el fibrinógeno en mayas de fibrina que atrapan plaquetas, células sanguíneas y plasma, formando el coágulo(4).
La activación de la coagulación se produce por la vía extrínseca con el daño tisular y la vía intrínseca actúa al afectarse la pared del vaso sanguíneo (Fig. 4).

Figura 4. Vía intrínseca y extrínseca. Activadores de la coagulación.
La hemorragia es un fenómeno relativamente frecuente en la infancia, por lo que es necesaria una buena historia clínica para diferenciar aquellas banales propias de la edad, de aquellas que pueden esconder un trastorno de la coagulación. Su cribaje estará indicado en: presencia de sangrado con signos de alerta (Tabla IV), previo a cirugía y en niños asintomáticos con historia familiar de trastorno de la coagulación(5).

Métodos de estudio
Se deben realizar pruebas que abarquen el estudio de la hemostasia primaria (número y función plaquetar) y de la coagulación plasmática: el tiempo de protrombina (TP), tiempo de tromboplastina activada (TTPA) y el fibrinógeno (Tabla V), siendo en la mayoría de los casos suficientes para realizar una aproximación diagnóstica(6,7) (Tabla VI).


Para una correcta valoración, es imprescindible recoger una buena muestra. Ésta se debe depositar en un tubo con citrato, con una proporción de una parte de citrato por nueve de sangre. Se debe rellenar hasta el límite indicado; ya que, si no se obtiene muestra suficiente, existiría un exceso de anticoagulante, dando tiempos de coagulación falsamente alargados. Otro caso son las muestras de pacientes poliglobúlicos en los que, al presentar una menor proporción de plasma, también encontraríamos un exceso de anticoagulante(8). La muestra debe mezclarse bien y analizarse en las primeras 2 horas o en las 4 primeras si la muestra se mantiene entre 2-4°C.
Tiempo de protrombina (TP)
Mide el tiempo de coagulación en presencia de un exceso de tromboplastina cálcica. Detecta deficiencias de los factores de la vía extrínseca y común: factores vitamina K dependientes (II, VII y X), factor V y fibrinógeno(9). El resultado puede expresarse de 4 maneras diferentes: comparando en segundos el TP del paciente con el TP control; expresado como INR (International Normalized Ratio), exclusivamente en pacientes tratados con dicumarínicos; como ratio (TP paciente/TP control); o como índice (TP control)/(TP paciente) x 100.
Tiempo parcial de tromboplastina activada (TTPA)
Mide el tiempo de coagulación mediante la adición de tromboplastina activada con caolín o ácido elágico y cloruro cálcico a la muestra. Permite explorar la vía intrínseca (factores VIII, IX, XI, XII, precalicreína y quininógeno de alto peso molecular), la vía común (factores II, V, X y fibrinógeno) y monitorizar el tratamiento con heparina.
Tiempo de trombina (TT)
Mide el tiempo de formación de fibrina en presencia de trombina humana o bobina. Se alarga cuando existen alteraciones del fibrinógeno, hiperfibrinolisis o heparina.
Tiempo de reptilasa (TR)
La reptilasa es un enzima similar a la trombina pero procedente de veneno de serpiente. Es útil para detectar si una muestra está contaminada con heparina ya que encontraremos un TT alargado con un TR normal.
Factor von Willebrand (FvW)
Es una proteína que participa en la hemostasia primaria contribuyendo a la adhesión plaquetar ante un endotelio lesionado y en plasma como transportador del factor VIII coagulante. Su alteración puede ser causa de sangrado, pudiendo ser las pruebas básicas de coagulación normales. Se debe solicitar conjuntamente con la dosificación de factor VIII y cofactor de la ristocetina.
Bibliografía
1. Bain BJ. Diagnosis from the blood smear. N Engl J Med. 2005; 353: 498.
2. Díaz de Heredia C, Bastida P. Interpretación del hemograma pediátrico. An Pediatr Contin. 2004; 2(5): 291-6.
3. Dallman PR. Developmental Changes in Number in leukocytes. En: Rudolph A, editor. Rudolph’s Pediatrics. 19th ed. New York: Appleton & Lange; 1991. p. 1142-3.
4. Guyton AC, Hall JE. Tratado de fisiología médica. 10th ed. Madrid: McGraw-Hill; 2001. p. 509-12.
5. Toll MT. Trastornos hemorrágicos de la coagulación. An Pediatr Contin. 2007; 5(4): 181-8.
6. Carnelli V, Dozzi M, Gibelli M, Giovaniello A, Riva F, Seidita C, et al. Children with hemorrhagic diathesis: correct diagnostic and therapeuthic approach. Pediatr Med Chir. 1990; 12(1): 13.
7. Tripodi A, Chantarangkul V, Mannuci PM. Acquired coagulation disorders: revisited using global coagulation/anticoagulation testing. Br J Haematol. 2009; 147(1): 77-82.
8. Adcock DM, Kressin DC, Marlar RA. Minimun specimen volume requeriments for routime coagulation testing: dependence on citrate concentration. AM J Clin Pathol. 1998; 109: 595.
9. Zehnder JL. Clinical use of coagulation tests. In: UpToDate. Basow, DS (Ed.), UpToDate, Waltham, MA, 2011.
